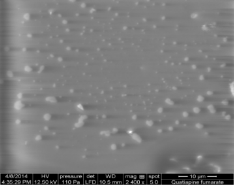

Int J Pharm Pharm Sci, Vol 6, Issue 7, 358-364Original Article
PREPARATION AND SOLID STATE CHARACTERIZATION OF NANOCRYSTALS FOR SOLUBILITY ENHANCEMENT OF QUETIAPINE FUMARATE
LAKSHMI PRASANNA GUBBALAa, SRINIVAS ARUTLAb, VOBALABOINA VENKATESHWARLUc
aIntegrated Product Development, Dr Reddys Laboratories Limited, Hyderabad, bHead-Product Development; Apotex Research Private Limited, Bangalore, cManaging Director, Neuheit pharma technologies Private Limited, Hyderabad.
Email: lakshmiprasannag@drreddys.com, glprassu@yahoo.co.uk
Received: 31 May 2014 Revised and Accepted: 12 Jul 2014
ABSTRACT
Objective: Quetiapine fumarate (QF) has poor water solubility and its oral bioavailability is observed to be 9% [1]. The objective of the present work is to prepare QF nanoparticles by wet media milling (WMM) and explore on the improvement in solubility with the aim of dose reduction and minimizing the side effects associated with its oral administration.
Methods: Nanoparticle of QF were prepared by WMM using sodiumlaurylsulphate (SLS), polyvinylpyrrolidone (PVP), hydroxypropylcellulose (HPC) and Hydroxypropylmethylcellulose (HPMC) as surface stabilizers. The nanosuspensions obtained were characterized for its mean particle size (MPS), zeta-potential (ZP) and Polydispersity-index (PI). Further lyophilized nanoparticles were characterized for MPS, ZP, PI, saturation solubility (SS), X-ray diffraction (XRD), Differential Scanning Calorimetry (DSC), Infra-Red (IR) and Scanning electron Microscopy (SEM).
Results: The MPS of the nanosuspensions obtained after 1 hour WMM and its lyophilized nanoparticlesis observed to be less than 1000 nm with PI ranges from 0.2 to 0.6 and negative ZP ranging from -30 to -36 mV. Lyophilized nanoparticles have shown significant improvement in SS when compared to plain drug. XRD and DSC have shown absence of the crystalline peaks and endotherm of QF respectively, indicating loss of its crystallinity. IR spectra showed no change in position of bands thus drug is compatible with surface stabilizers used. SEM photographs confirmed the formation of nanoparticles.
Conclusion: From the above results it has been concluded that by subjecting QF to WMM, QF nanoparticles were obtained with significant improvement in saturation solubility and drug losing its crystalline nature when compared to plain drug.
Keywords: Quetiapine Fumarate, Nanosuspension, Wet media milling, Lyophilized nanoparticles.
INTRODUCTION
A significant percentage of active pharmaceutical ingredients identified through discovery screening programs are poorly soluble in water. These molecules are often difficult to formulate using conventional approaches and are associated with innumerable formulation-related performance issues, e.g. poor bioavailability, lack of dose proportionality, slow onset of action and other attributes leading to poor patient compliance[2]. Most of the synthetic drug available so far in market are either weakly acidic or basic in nature, such molecules possess narrow range of absorption profile [3], when administered orally for systemic therapies. The erratic and poor absorption of these molecules are closely related with different physiological pH of gastrointestinal tract. Poor solubility in water correlates with poor bioavailability. If there is no way to improve drug solubility it will not be able to be absorbed from the gastrointestinal tract into the bloodstream and reach the site of action. A major hurdle that has prevented commercialization of many promising poorly soluble drugs is dissolution rate limited bioavailability [4]. There is a continuous need for improving bioavailability of such molecules.
The conventional approaches to solve the problems of low solubility and low bioavailability include micronization, use of fatty solutions, use of penetration enhancer or co-solvents, surfactant dispersion method, salt formation, precipitation, etc., but still, these techniques having limited utility in solubility enhancement for poorly soluble drugs. Additional approaches are vesicular system like liposomes, dispersion of solids, emulsion and micro-emulsion methods, and inclusion complexes with cyclodextrins, which show beneficial effect as drug delivery system but major problems of these techniques are lack of universal applicability to all drugs [5]. Nanoparticles are gaining the pharmaceutical industry’s attention as research and practical experience demonstrate their many uses. [6]. The oral, parenteral, transdermal, transmucosal, ocular, and pulmonary drug-delivery routes can effectively use nanoparticles, and implants can incorporate these particles, too. In a 2007 study, research firm Fredonia Group concluded that demand for nanotech-based medical supplies and devices in the US will exceed a value of $110 billion by 2016.
Over the last decades, nanoparticle engineering has been developed and has been reported for pharmaceutical applications [7]. The various advantages of nanosuspension include, enhance the solubility and bioavailability of drugs, suitable for hydrophilic drugs, higher drug loading can be achieved, dose reduction is possible, enhance the physical and chemical stability of drugs, provides a passive drug targeting [8].
Drug nanocrystals are one of the most important strategies to enhance the oral bioavailability of the hydrophobic drug. Drug particle size reduction has been often used to enhance the solubility as per Noyes-Whitney equation [9]. Increasing surface area by producing smaller drug particles is one of the main strategies to improve the solubility and/or bioavailability but the smaller particles aggregate and reduce the surface area for wetting and dissolution. Hence stabilizing the nanoparticles poses challenge in the development of nanoformulations [10].
Creating nanoparticles can be challenging and requires appropriate equipment and techniques. There are various ways in which nanoparticles of poorly water-soluble molecules are generated such as a) Wet Media Milling/ WMM (also called as bead milling or pearl milling or nano milling) b) High pressure homogenization, c)Solvent evaporation, d) Nanoprecipitation, e) Emulsification/solvent, f)diffusion, g) Salting out, h) Dialysis, i) Supercritical fluid technology (SCF) [11].
Bead or Pearl milling is perhaps the most established technique for the production of drug nanocrystals and has been described in detail in several recently published reviews [12, 13, 14 ]. Media milling or wet grinding is the best-established manufacturing method for nanoparticle production. Its many benefits include, excellent particle-size control, cost-effectiveness, equipment scalability from bench-top to production, limited or no contamination of the active ingredient, process repeatability, fulfillment of current good manufacturing practice production requirements. Media milling involves the use of various milling media such as zirconia, and glass balls/beads to reduce the particle size of the compounds and produce sub-micron particle dispersions [15].In brief, pearl milling involves the continuous stirring and wet milling of aqueous drug slurry with specialized—and extremely hard and durable milling beads. Nanocrystals which are smaller than 1000 nm in diameter may be produced, and particle size reduction is achieved via a combination of high-energy shear and impaction forces between the milling pearls and the solid drug particles. The addition of a surface stabilizer(s) to the aqueous drug slurry is essential as this attenuates the increase in free energy associated with the creation of new particle surface and prevents nanocrystals aggregation.
With the proper stabilizing agents, bead mills efficiently disperse output to discrete, sub micrometer particle-size, stable dispersion. In bead mills, impact and shearing forces between moving beads grind suspended solid particles. The agitator shaft within the machine’s stator housing transmits kinetic energy to the grinding media.Stress intensity and the number of contact points are the main factors that determine particle fineness. Stress intensity is influenced by the kinetic energy in the grinding beads. To produce a fine particle-size distribution, a process must have a high number of contact points. The smaller the grinding media, the more contact points touch the product. Mostly the particle size achieved by media milling is equal to 1/1000 the size of the grinding media.
The formulation consists only of water, drug and one or more excipients acting as surface stabilizers. Typically, on average, the drug to stabilizer ratio on a weight basis ranges from 1:1 to 20:1. These liquid nanosuspension exhibit acceptable shelf-life and can be post-processed into various types of solid dosage forms. Nanoparticulate based drug products have been shown to improve bioavailability and enhance drug exposure for oral and parenteral dosage forms. Quetiapine is an psychotropic agent used for treatment of schizophrenia, bipolar disorder and major depressive disorder.
During the Fourth Quarter of 2009 quetiapine ranked third on the list of top 40 brand name drugs. Adverse metabolic effects of atypical antipsychotics include diabetes mellitus, lipid abnormalities, weight gain, metabolic and cardiovascular effects. The relative risk of glucose intolerance/diabetes mellitus, hyperlipidemia and hyper-leptinemia are moderately high for quetiapine[16].The recommended dosage of quetiapine is 800 mg per day. Fatal overdoses associated with quetiapine have been reported [17].
Quetiapine was BCS Class IV drug having low solubility and low permeability so to solve this problem Fumarate salt was prepared which increase the permeability of Quetiapine but solubility remains the same. Thus Quetiapine was converted to Quetiapine Fumarate which is a BCS Class II drug having low solubility and high permeability, thus making it suitable for nanosizing. Quetiapine fumarate is a weak acid which exhibits moderate pH dependent solubility and lipophilicity characteristics, thus quetiapine shows pH dependent solubility i.e. it is soluble in acidic aqueous media but solubility of drug decreases with increase in pH of media. However its oral bioavailability has been reported to be 9 %. In the present study, an attempt is made to improve the solubility of QF by reducing the particle size to nanosize (i.e. below 1000 nm). Wet Media Milling technique was used to prepare nanoparticles and study its characterization data. The nanoparticles prepared were characterized for particle size, zeta potential and saturation solubility to confirm improvement in the solubility and also characterized by XRD, DSC, IR and SEM to study the morphology of quetiapine fumarate before and after particle size reduction.
MATERIALS AND METHODS
Quetiapine fumarate was obtained from Dr Reddys laboratories limited, Hydroxy propyl methylcellulose (HPMC 6 cps) supplied by Colorcon Private Limited, polyvinylpyrrolidone (PVP) supplied by BASF, hydroxyl propyl cellulose (HPC) supplied by Hercules, sodium lauryl sulfate(SLS) supplied by JRS. All other chemicals and solvents used are of analytical grade.
Preparation of Nanoparticles
QF nanosuspensions were prepared by using different surface stabilizers such as SLS, PVP, HPC and HPMC as indicated in Table 1. Drug suspensions were prepared by dissolving SLS and polymer stabilizers (PVP/HPMC/HPC) in small quantity of purified water with stirring. To this drug QF was dispersed in small quantities with slow stirring. The drug suspension was subjected to high shear homogenization for about 10 minutes to prevent any lump formation and uniform mixing. The drug suspension was then subjected to size reduction by using WMM technique.
QF nanosuspensions were prepared by using a bead mill (Model: Lab Star 1, NietzscheMill and Germany). The milling chamber was charged with the milling or grinding media comprising of 0.5 mm Yttrium stabilized zirconium beads that constituted up to 80% occupancy of chamber. The milling operation was performed in a re-circulation mode with the suspension fed at a rate of 115 gram per minute. The mill and pump speeds were set at 1800 and 50 rpm respectively. The suspension flowed axially through the milling chamber where the shear forces generated during impaction of the milling media with the drug provided the energy input to fracture the drug crystals into nanometer-sized particles. The temperature inside the milling chamber was maintained at 20 ± 2°C by circulating cooling water through the outer jacket. After milling, the suspension was collected and stored at a temperature below 25°C until further processing. Initial sample (i.e. before milling) and for every 15 minutes the sample has been collected for particle size and zeta potential analysis.
Table 1: Composition of quetiapine nanosuspension
| Formulation | Drug (%) | SLS | PVP | HPC | HPMC | Water |
| QF-01 | 5 | 1 | 3 | - | - | qs |
| QF-03 | 5 | 1 | - | - | 3 | qs |
| QF-07 | 5 | 1 | - | 3 | - | qs |
Production of dry nanoparticles
The nanosuspensions prepared were lyophilized using lyophilizer. The samples were kept in deep freezer at -70 °C overnight and kept in lyophilizer at -33 °C for about 11.25 hours, -5 °C for 24 hours,20 °C for 3 hours and 40 °C for 11 hours. Total freeze drying cycle time is not less than 42.28 hours.
Characterization of nanosuspension and lyophilized nanoparticles
The particle size, particle size distribution, and zeta potential affect the safety, efficacy, and stability of nanodrug delivery systems as well as solubility is also altered by solid state of nanoparticles. Thus, characterization of nanoparticles plays a great role in forecasting in vitro and in vivo performance of nanodrug delivery systems. In vivo pharmacokinetic performance and biological function of nanosuspension strongly depends on its particle size and distribution, particle charge (zeta potential), crystalline state, and particle morphology[18].
Particle size analysis
The MPS and particle size distribution (PSD) affects saturation solubility of nanoparticles. The particle size distribution and its range named Polydispersity index (PI) can be determined by laser diffraction (LD), photon correlation spectroscopy, microscope, and coulter counter [19].PI gives the physical stability of nanosuspensions and should be as lower as possible for the long-time stability of nanosuspensions. A PI value of 0.1 to 0.25 shows a fairly narrow size distribution and PI value more than 0.5 indicates a very broad distribution [20].
The particle size distribution of suspension before (initial), during (at different time intervals of milling ie 15 minutes, 30 minutes, 45 minutes) and completion of milling (60 minutes)were determined using Malvern Zetasizer Nanoseries nano-ZS. The particle diameter reported was calculated based on size distribution by intensity. A refractive index of 1.65 has been used for measurements. The particle size obtained with different stabilizer compositions was evaluated. The nanosuspension was diluted with water to obtain suitable concentrations for measurement. Diluted nanosuspension was added to the sample cell (quartz cuvette) and put into sample holder unit and measurement was carried out with help of software. The particle size of drug in lyophilized sample was analyzed by adding water to lyophilized sample (so that the surface stabilizers are in dissolved state and only drug in dispersed form) followed by dilution with water to obtain suitable concentrations for measurement.
Zeta potential
A prerequisite to achieve an enhancement of oral bioavailability with drug nanocrystals is that crystals are finely dispersed in the gut and do not aggregate. In case they start aggregation, the bioavailability decreases with increasing aggregate formation. This is attributed to the fact that they lose special properties of nanoparticles such as their adhesive property to the mucosal wall. Therefore it is necessary to prepare nanosuspensions with a physical stability as high as possible. Surface charge properties of the nanosuspensions are studied through zeta potential. The value of particle surface charge indicates the stability of nanosuspensions at the macroscopic level. A minimum zeta potential of ±30 mV is required for electrostatically stabilized nanosuspensions [21, 22] and a minimum of ±20 mV for steric stabilization [23]. The zeta potential values are commonly calculated by determining the particle's electrophoretic mobility and then converting the electrophoretic mobility to the zeta potential [24].
Zeta potential of the suspension before, during and after milling has been analyzed in Malvern zeta sizer after diluting nanosuspension with water to obtain suitable concentration for measurement. Water was added to the lyophilized samples and diluted with water to obtain suitable concentration for measurement. Zeta potential of the optimized formulation was measured using the same instrument. Sample was added in specialized zeta cell and the same procedure as that of particle size was carried out.
Saturation Solubility
Saturation solubility was carried out in different media (different pH) conditions using rotary shake flask method. Different pH media’s include 0.1 N hydrochloric acid (HCl), 4.5 phosphate buffer, 6.8 phosphate buffer and purified water. Excess amount of drug and lyophilized nanoparticles have been added to 100 ml of media maintained at 37 °C and shaken on rotary shake flask for a period of 24 hours. The samples were taken into centrifuge tube and centrifuged for about 10 minutes at 4000 rpm.
The supernatant was diluted with diluent (methanol and acetonitrile in 1:1 ratio)and analyzed using HPLC (Waters Alliance HPLC system, USA) method. The mobile phase consists of mixture of potassium dihydrogen orthophosphate, acetonitrile, tetrahydrofuran, triethyl amine pH adjusted to 6.4 with KOH solution. Chromatographic separation was accomplished using an Xterra Column RP8 3.5 µm; 4.6X150 mm column. The mobile phase was pumped isocratically at a flow rate of 1.5 mL/minute during analysis and maintained at a column temperature of 50°C.
Powder X-day diffraction [PXRD]
Polymorphic or morphological changes of nanosized particles can be checked by assessing the crystalline state and particle morphology [25].As nanosuspension formation experiences high attrition during bead milling, change in crystalline structure of formulation occurs which may be converted to either amorphous or other polymorphic forms [26,27] Alteration in the solid state of the drug particles and the extent of the amorphous portion is determined by X-ray diffraction analysis [28] and supplemented by Differential Scanning Calorimetry analysis. The X-ray diffractograms of QF and the lyophilized nanoparticles were recorded using a Panalytical X-pert Pro, Diffractometer, Netherlands) with a Cu line as the source of radiation. Standard runs using a 40 kV voltage, a 40mA current and a scanning rate of 0.02°min−1 over a 2θ range of 3 – 45° were used
Differential Scanning Calorimetry [29]
Thermal characteristics of the QF, physical mixtures of QF, PVP, SLS and lyophilized nanoparticles were studied.Thermal properties of powder samples were investigated using a Perkin-Elmer DSC-7 differential scanningcalorimeter / TAC-7 thermal analysis controller with an intracooler-2 cooling system (Perkin- ElmerInstruments, USA). For evaluation about 3 to 5 mg of product was placed in perforated aluminumsealed 50 microliterpans and the heat runs for each sample was set from 20 to 200°C at 10°C/minute, an inertenvironment was maintained using nitrogen.
Fourier Transforms Infra –Red Spectroscopy
The infrared spectra are recorded on Fourier Transform Spectrometer in mid infrared with in the range (400-4000 cm-1). Due to the complex interaction of atoms with in the molecule, IR absorption of the functional groups may vary over a wide range. However, it has been found that many functional groups give characteristic IR absorption at specific narrow frequency range. Multiple functional groups may absorb at one particular frequency range but a functional group often gives rise to several characteristic absorptions. Stretching & bending vibrations are varied after formulation can be observed. Thus, the spectral interpretations should not be confined to one or two bands only actually the whole spectrum should be examined [30,31].
FT- IR spectra of quetiapine fumarate, excipients and lyophilized samples were recorded on the sample prepared in Potassium Bromide (KBr) disks, wherein sample and KBr are taken in 1:100 ratio) using Shimadzu Fourier Transform Infra-Red spectrometer. The samples were scanned over a frequency range 4000-400 cm-1.
Scanning electron Microscopy
Scanning electron microscopy is a type of electron microscopy that images the surface of solid specimen by using focused beam of high-energy electrons. Scanning electron microscopy (SEM) is giving morphological examination with direct visualization. The techniques based on electron microscopy offer several advantages in morphological and sizing analysis; however, they provide limited information about the size distribution and true population average. For SEM characterization, nano particles solution should be first converted into a dry powder, which is then mounted on a sample holder followed by coating with a conductive metal.
The sample is then scanned with a focused fine beam of electrons [32].The electrons which are scattered and/or generated through secondary processes, are collected through secondary electron or back-scattered electron detectors. The backscattered electron images are sensitive to the atomic weight of the elements present. The regions of the image which appear brighter indicate the presence of high atomic weight elements. The surface characteristics of the sample are obtained from the secondary electrons emitted from the sample surface. The nanoparticles must be able to withstand vacuum, and the electron beam can damage the polymer[33].
Quetiapine Fumarate or the lyophilized sample powder was placed on the Carbon tape stuck to the Aluminum SEM stub. Later it was imaged in the SEM at a low vacuum. The particle size analysis of lyophilized Nanosuspension was carried out to confirm the nano-size of formulation.The nanosuspension of quetiapine fumarate prior to lyophilization was also analyzed by scanning electron microscopy to study the surface properties. Nanosuspension was dried on thin glass slide which is placed on the Carbon tape stuck to the Aluminum SEM stub. Later it was imaged in the SEM at a low vacuum.
RESULTS AND DISCUSSION
Nanoparticles of QF were successfully prepared by wet media milling technique. The obtained nanoparticles have been assessed for particle size analysis, zeta potential, saturation solubility and solid state characterization by XRD, DSC, IR and SEM analysis.
Particle size analysis
The particle size of the nanosuspension and the lyophilized nanoparticles was analyzed by zeta sizer. All samples at different time points of milling were analyzed for particle size after dilution with water. The MPS (nm) and PI of nanosuspensions at different time points of milling is represented in (Table 2).
From the results it could be inferred that after 1 hour of WMM the particle size in the nanosize was obtained.
The MPS obtained after 60 minutes of WMM is ranging from75 nm to 409 nm and PI is ranging from 0.2 to 0.6. The particle size distribution pattern of QF-01 after 60 minutes WMM with MPS of 75.3 nm is shown in figure 1.
Table 2: Mean particle size (MPS) and Polydispersity index (PDI) of nanosuspensions
| Nanosuspensions | Initial | 15 min | 30 min | 45 min | 60 min | |||||
| MPS (nm) | PDI | MPS (nm) | PDI | MPS (nm) | PDI | MPS (nm) | PDI | MPS (nm) | PDI | |
| QF-01 | 1728 | 0.930 | 649 | 0.57 | 231.6 | 0.283 | 209.9 | 0.27 | 75.3 | 0.28 |
| QF-03 | 2324 | 1.0 | 924 | 0.71 | 494 | 0.627 | 385.6 | 0.643 | 305 | 0.61 |
| QF-07 | 1928 | 1.0 | 860 | 0.71 | 741 | 0.873 | 663 | 0.53 | 409.4 | 0.565 |

Fig. 1: Particle size graph of QF-01after 60 minutes of WMM
The MPS (nm) and PI of dried nanoparticles obtained after lyophilization of nanosuspensions prepared is represented in (Table 3).
Table 3: Mean particle size (MPS) and Polydispersity index of Quetiapine nanoparticles
| Time points | QF-01 | QF-03 | QF-07 | |||
| MPS(nm) | PDI | MPS(nm) | PDI | MPS(nm) | PDI | |
| 60 minutes | 163 | 0.5 | 325 | 0.4 |
Zeta potential
Zeta potential of nanosuspensions prepared by using and electrostatic stabilizer (SLS) and steric stabilizers (PVP/HPC/HPMC) was measured using zeta sizer. The zetapotential of the nanosuspensions and lyophilized nanoparticles measured has been tabulated in (Table 4).
Zeta potential of the nanosuspension was found to be more than -30 mV (in the range of -30 mV to -36 mV) indicating the stability of the nanosuspensions formed. Further the zeta potential of the lyophilized nanoparticle prepared for batch QF-01 was observed to be -34 mV as shown in figure 2, indicating the stability of the lyophilized nanoparticles obtained.
Table 4: Zeta potential (-mV) of the Quetiapine nanosuspensionsand Quetiapine nanoparticles
| Time (minutes) | QF-01 | QF-03 | QF-07 |
| Quetiapine Nanosuspension | |||
| Initial | 36 | 30 | 31.4 |
| 60 | 32 | 32 | 32.5 |
| Quetiapine Nanoparticles [Lyophilized] | |||
| 60 minutes | 34 | - | - |

Fig. 2: Zeta potential distribution of lyophilized nanoparticles from batch QF-01
The narrowest particle size distribution and smallest particle size of nanosuspensions was observed for composition with SLS and PVP as surface stabilizers ie batch QF-01 with SLS and PVP as stabilizers achieved particle size 75.3 nm after 60 minutes of media milling and the zeta potential before and after lyophilization more than -30 mV which is attributed to better stability. Hence batch QF-01 has been taken forward for saturation solubility analysis and solid state characterization.
Saturation Solubility
The Saturation solubility of pure drug and lyophilized nanoparticles from QF-02 was evaluated in 0.1N HCl, phosphate buffer pH 4.5, phosphate buffer pH 6.8 and water at physiological temperature (37°C). The higher solubility in acidic pH (0.1N HCl) condition as compared to phosphate buffer pH 6.8 or water could be attributed to the pH dependent solubility of quetiapine fumarate. It has been observed that the saturation solubility of lyophilized nanoparticles was significantly higher than as-is drug at all pH conditions as shown in Figure 3.

Fig. 3: Saturation solubility of Quetiapine Fumarate and Quetiapine lyophilized nanoparticles.
Solid state characterization
Quetiapine fumarate, Quetiapine lyophilized nanoparticles has been subjected to various solid state characterizations such as XRD, DSC, IR and SEM analysis.
X-day diffraction [XRD]
The presence of numerous distinct peaks in the X-ray diffraction pattern indicate that QF as crystalline material with characteristic diffraction peaks appearing at a diffraction angle of 2θ at 7.4, 16.26, 20.1, 23.29& 38.23. The powder X-ray diffraction pattern of the quetiapine fumarate is shown in (Figure 4A) and quetiapine lyophilized nanoparticlesis shown in (Figure4B). From the data it has been observed that quetiapine lyophilized nanoparticles showed complete absence of the characterized peaks of quetiapine fumarate. The results indicate that quetiapine fumarate is no longer in crystalline form when processed by WMM.

A

B
Fig. 4: XRD pattern of A [QF], B[lyophilized nanoparticles]
FTIR Spectroscopy
Figure 5 shows that IR spectrum of the QF (5A), SLS (5B), PVP (5C), physical mixture of SLS+PVP (5D), physical mixture of QF+SLS+PVP (5E) and the Quetiapine lyophilized nanoparticles (5F). The characteristic peaks of QF observed at 3310 cm-1may be due to O-H stretching, 3080 cm-1 may be due to Ar-H stretching; 2880 cm-1 due to C-H stretching, 1600 cm-1 may be due to C-N, 1597, N-H bending;1340 cm-1 maybe due to C-H; bending, 1070 cm-1 C-C stretching, 1030 cm-1 may be due to –C-O-C group, 791 cm-1 may be due to substituted benzene ring; The peaks of 1647, 1463 and 1294 cm-1 are assigned to the C=O stretching, CH2 bending and C-N stretching vibration, respectively in the PVP. The absorption peaks at 1407 cm -1may be attributed to -S-O stretching of sodium lauryl sulphate. From the IR spectrums of the QF, individual excipients, physical mixture and the lyophilized nano particles, it has been observed that there is no appreciable change in the positions of the characteristic bands of the drug either in physical mixture or during lyophilization. Since there is no change in the nature and position of the bands in the formulation, it can be concluded that the drug maintains its identity without going any chemical interaction with the surface stabilizer used.

A

B

C

D

E

F
Fig. 5: IR spectra of A [QF]; B [SLS]; C [PVP]; D [PM of SLS+PVP]; E [PM of QF+ SLS+PVP]; F [lyophilized nanoparticles]
Differential Scanning Calorimetry
The DSC thermograms of pure drug quetiapine fumarate, physical mixture of QF+PVP+SLS and lyophilized nanoparticles were obtained as shown in figure 6. The thermograms obtained by DSC studies, reveal that the melting point of pure drug QF is 175 °C. The physical mixture gave melting endotherm at 170 °C for QF and broad melting endotherm at 74.89 for PVP.
The thermogram of lyophilized nanoparticles haveshown broad endotherm only at 70 °C and complete absence of endotherm related to QF indicating the loss of drug crystallinity of drug. These results confirm that QF is no longer present as crystalline form when processed by WMM.

Fig. 6: DSC thermograms of drug QF (A), physical mixture (B) and lyophilized nanoparticles (C)
Scanning Electron Microscopy [SEM]
Pure drug quetiapine fumarate, nanosuspension and its lyophilized nanoparticles were been analyzed for surface appearance, particle size and shape by Scanning electron microscopy. Pure quetiapine fumarate showed crystalline particles with particle size ranging from 12 to 44 microns. SEM photograph of quetiapine fumarate at higher magnification (A) and lower magnification are shown in Figure 7.


A B
Fig. 7: SEM Photographs of Quetiapine Fumarate at different magnification
The SEM photographs of the nanosuspensions were also obtained. The SEM photographs of the nanosuspensions at higher (A) and lower (B) magnification are shown in Figure 8.The SEM photographs of nanosuspension clearly indicate the change in the morphology of QF wherein crystalline irregular shaped particles of QF changed to spherical particles. The SEM photographs of the lyophilized nanoparticles were also obtained at lower (A) and higher (B) magnification as shown in Figure 9. The lyophilized nanoparticles when analyzed by SEM confirmed the formation of nanoparticles of quetiapine fumarate wherein particle size less than 1000 nm (ranging from 412 nm to 847 nm).

A B
Fig. 8: SEM Photograph of nanosuspensions at different magnification


A B
Fig. 9: SEM photograph of theQuetiapine lyophilized nanoparticles
The SEM photographs of dried nanosuspension (as shown in Figure 8) and lyophilized nanoparticle (as shown in Figure 9) illustrate the stabilizers (PVP and SLS) precipitated around the drug nanoparticles during water removal process (i.e. lyophilization), thus creating highly hydrophilic environment around quetiapine fumarate and preventing particle interaction.
CONCLUSION
In this study quetiapine nanoparticles were successfully prepared by wet media milling and were evaluated for its various solid state characteristics. Wet media milling was shown to be simple and adequate operation for particle size reduction. Through various studies performed it was found that crystalline quetiapine fumarate lost its crystallinity and shown improved saturation solubility. The increase in the solubility can be expected to have a significant impact in the oral bioavailability of the drug. This study shows the effectiveness of the wet media milling technique as a promising approach for enhancement of the solubility of poorly soluble drug like quetiapine fumarate.
ACKNOWLEDGEMENTS
The authors would like to thank “Dr Reddys Laboratories Limited” for allowing me to conduct experiments and generate the data.
CONFLICT OF INTEREST
Conflict of interest declared none.
REFERENCES
- Goren JL, Levin GM. Quetiapine, an atypical antipsychotic. Pharmacotherapy 1998;18(6):1183-94.
- Merisko-Liversidge E, Liversidge GG. Nanosizing for oral and parenteral drug delivery: A perspective on formulating poorly-water soluble compounds using wet media milling technology.Advanced Drug Delivery Reviews2011;63(6):427-40
- Haresh T, Nehal I, J. Mulani1, and In Vitro Evaluation of pH-Independent Sustained Release Drug Delivery System of Quetiapine Fumarate. International Journal of Pharmaceutical Innovations 2011;1(2):59-75.
- Deecaraman M, Rani C. ArunkumarN, Nanosuspension technology and its applications in drug delivery. Asian Journal of Pharmaceutics 2009;3(3):168-73.
- Lakshmi P, Ashwini KG. Nanosuspension technology:A review. Int J Pharm PharmSci,2010;2:35–40
- Chris W. Harry The Challenges of Manufacturing Nanoparticles through Media Milling;Pharmatech Talk:Equipment and Processing Report. Advanced drug delivery reviews 2008.
- Vermaa S, Lan Y, Gokhale R, Burgessa DJ, J. Quality by design approach to understand the process of nanosuspension preparation. Int 377 18598 2009:1-2.
- Liversidge GG, Cundy KC, J. Particle size reduction for improvement of oral bioavailability of hydrophobic drugs:Absolute oral bioavailability of nanocrystallinedanazol in beagle dogs. Int 1995;125:91-7.
- Hintz RJ, Johnson KC. The effect of particle size distribution on dissolution rate and oral absorption. Int J Pharm 1989;51:9-17.
- Metallopolymer NanocompositesSpringer Series in Materials Science. Principles and Mechanisms of Nanoparticle Stabilization by Polymers 2005;81:65-113.
- Nagavarma B, Hemant S, Ayaz A, Vasudha L, S. K, Shivakumar HG, et al. V N, Different techniques for preparation of polymeric nanoparticles-A review. Asian Clin Res 5 Suppl 3;2012:16-23.
- W. B. N. Rasenack, Micron-size particles:common and novel micronization techniques. PharmDevTechnol 2004;9(1):1-13.
- Peltonen L, Hirvonen J. Pharmaceutical nanocrystals by nanomilling:critical process parameters, particle fracturing and stabilization methods. The Journal of pharmacy and pharmacology 2010;62(11):1569-79.
- Merisko-Liversidge E, Liversidge GG. Nanosizing for oral and parenteral drug delivery:a perspective on formulating poorly-water soluble compounds using wet media milling technology. Advanced drug delivery reviews 2011;63(6):427-40.
- Verma S, Lan Y, Gokhale R, Burgess DJ. Quality by design approach to understand the process of nanosuspension preparation. Int J Pharm 2009;377(1-2):185-98.
- Melkersson K, Dahl M-L. Adverse metabolic effects associated with atypical antipsychotics:literature review and clinical implications. Drugs 2004;64(7):701-23.
- Langman LJ, Kaliciak HA, Carlyle S. Fatal overdoses associated with quetiapine. J Anal Toxicol 2004;28(6):520-5.
- Vishal R, J. Patel and Y. K AgrawalNanosuspensionAn approach to enhance solubility of drugs Pharm Technol Res 2011;2(2):81-7.
- Kumar AN, Deecaraman M, Rani C. Nanosuspension technology and its applications in drug delivery.Asian J Pharm. 2009;3:168-73
- Chen Y, Liu J, Yang X, Zhao X, Xu H. Oleanolic acid nanosuspensions:preparation, in-vitro characterization and enhanced hepatoprotective effect. The Journal of pharmacy and pharmacology 2005;57(2):259-64.
- Jacobs C, Müller RH. Production and characterization of a budesonide nanosuspension for pulmonary administration. Pharm Res 2002;19(2):189-94.
- Yang JZ, Young AL, Chiang P-C, Thurston A, Pretzer DK. Fluticasone and budesonide nanosuspensions for pulmonary delivery:preparation, characterization, and pharmacokinetic studies. J Pharm Sci 2008;97(11):4869-78.
- Liang YC, Binner JG. Effect of triblock copolymer non-ionic surfactants on the rheology of 3 mol% yttriastabilised zirconia nanosuspensions. Ceram Int 2008;34(2):293-7.
- Muller RH, Grau MJ, World APV, Meeting A. Increase of dissolution rate and solubility of poorly water soluble drugs as nanosuspension. Proceedings Paris 1998;2:62-624.
- Young TJ, Mawson S, Johnston KP, Henriksen IB, Pace GW, Mishra AK. Rapid expansion from supercritical to aqueous solution to produce submicron suspensions of water-insoluble drugs. Biotechnol Prog 2000;16(3):402-7.
- H. A, Rainer H, J. Jens-Uwe and Müller.Nanocrystal technology, drug delivery and clinical applications. Int 2008;3(3):295-310.
- Kumar AN, Deecaraman M, Rani C. Nanosuspension technology and its applications in drug delivery.Asian J Pharma.2009;3:168-73.
- Setler P, R. II. London. Identifying new oral technologies to meet your drug delivery needs for the delivery of peptides and proteins and poorly soluble molecules. Drug delivery system 1999.
- Kocbek P, Baumgartner S, Kristl J. Preparation and evaluation of nanosuspensions for enhancing the dissolution of poorly soluble drugs. Int J Pharm 2006;312(1-2):179-86.
- Silverstein RM, Webster FX. Spectrometric Identification of Organic, Compounds, 6th ed, Jhon Wiley and Sons,;, p 72-1262002. 71-109.
- AshutoshKar, Text book of Pharmaceutical Drug Analysis, 2nded, new Age International Publishers;;p2005. 293-311.
- Jores K, Mehnert W, Drecusler M, Bunyes H, Johan C, Mader K, et al. Investigation on the stricter of solid lipid nanoparticles and oil-loaded solid nanoparticles by photon correlation spectroscopy, field flow fractionation and transmission electron microscopy. Release 2004;17:217-27.
- SovanLal PK, Manna GP, Mohanta R, Utpal P. Manavalan. Journal of Applied Pharmaceutical Science. Advanced drug delivery reviews 2011;01(06):228-34.